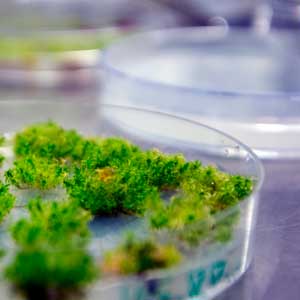

Contact
 Professor Hans Ronne
Professor Hans Ronne
Department of Forest Mycology and Plant Pathology
018-673223, hans.ronne@slu.se
Scientists at SLU has for the first time successfully adapted a gene technology developed in yeast for use in plants. This opens the door for using these powerful tools to study entire pathways of genes involved in plant specific processes such as photosynthesis, plant development and symbiotic interactions with other organisms.
Molecular techniques have during the past 40 years made it possible to study the function of individual genes. A fundamental principle is to either delete, “knock out”, or overexpress genes and observe the consequences. The commonest way to introduce new genes in a cell is to insert them in a plasmid, a small circular DNA-molecule, which is transformed into the host.
This kind of work relies heavily on so called model organisms, the “pet” of the laboratory. An ideal model organism is well-studied with a fully sequenced genome, grows and replicates quickly, thrives on simple media, withstands long-time storage etc. The basic model organism for bacteria is E. coli while baker’s yeast has been used for a long time to study fundamental biological processes in higher organisms (fungi, animals, plants).
A problem with these simple model organisms, however, is that every gene simply is not possible to express in yeast or bacteria. For example, genes involved in photosynthesis requires a model organism from the plant kingdom as a host. Common molecular biology techniques have traditionally been less effective in plants, among other reasons because the plasmid tends to integrate into the host genome and change (rearrange) in various way. The modification is thus not stable.
A breakthrough in this regard came in 1997, when it was shown that it is possible to knock out genes in the moss Physcomitrella patens in the same way as in yeast. The moss’ position as model organism was further strengthened in 2009, when a group presently at SLU discovered that plasmids introduced into moss do not integrate into the plant DNA or rearrange but remain intact. This means they can be used to overexpress interesting genes, but what is more important is that they can also be re-isolated from the moss (rescued) and thus used as so called shuttle plasmids.
A shuttle plasmid is a plasmid that may be moved between organisms – for example, from E. coli to moss and back to E. coli – without changing in the process. The moss may be transformed by a full genome library of such plasmids; i.e. plasmids containing copies of every gene from the plant of interest. The transformed moss cells expressing the genes of interest are retained. The shuttle plasmid is rescued back into E. coli and sequenced, studied and frozen for long time storage.
Another advantage of shuttle plasmids is so called dosage suppression, which may be used to find and study genes involved in the same biological process. A gene with known function is knocked out in yeast, disrupting the function. The yeast cells are then transformed with a gene library, and the cells that regain the lost function are kept. The plasmids are rescued back to E. coli and studied. This approach often reveals several different genes active in the same process that counter the effect of the knocked gene, which allows for analyzing how an entire battery of genes work together in a process. Shuttle plasmids in moss enables this powerful technique in plants.
A key step in every transformation is selection, meaning a mechanism that separates cells that are not transformed from those that are. The most common approach is antibiotic resistance; the plasmids contain a gene conferring resistance and the transformed cells are placed on a medium containing an antibiotic. The cells that are able to grow carry the plasmid. The method has limitations; the amount of available resistance genes is limited which hampers the possibility of selection in several dimensions simultaneously, and the antibiotics might also have unknown impact on the cells even though the resistance gene allows them to grow. For these reasons it is often advantageous to use auxotrophic markers instead. These are based on cell lineages where the ability to synthesize certain amino acids or nucleotides have been disrupted, and thus only grow on medium containing these. The plasmids carry genes that complement the deleted genes.
In a new study from the Department for Forest Mycology and Plant Pathology at SLU, it is demonstrated for the first time that auxotrophic markers may be used for molecular cloning of genes in Physcomitrella. Professor Hans Ronne has lead the project.
- We have previously seen that several techniques developed in yeast, such as gene targeting through homologous recombination and overexpression using stable plasmids work well in this moss. In the present study, we show that it is also possible to use auxotrophic markers, which gives us the opportunity to develop a sophisticated system of shuttle plasmids in this model organism, says Hans.
Hans and his colleagues knocked out the gene PpHIS3, which is essential for the moss’ ability to synthesize the amino acid histidine. The modified cells could subsequently only grown on histidine-enriched medium.
- When transforming the cells with a plasmid containing an intact PpHIS3-gene, they grow as normal on medium without histidine, says Hans. This makes this gene suitable as a selection marker in Physcomitrella. We were also able to knock out another gene, needed for the synthesis of tryptophan. This convinces us that it is feasible to create a large number of auxotrophic selection markers, far more than the four antibiotic resistance markers available for work in this organism presently.
When the scientists rescued the plasmid from the moss after the selection, it was identical to the plasmid transformed into the moss, i.e. it was not integrated into the moss genome or subjected to recombination.
- These findings together give us hope that Physcomitrella may be used to clone genes through complementation with a plasmid gene library. This would be a great step forward, since it would among other things allow us to conduct dosage suppression studies on interesting plant specific genes and functions. This has been done many times in yeast, but the lack of suitable shuttle plasmids has so far prevented this approach in plants. We hope that our discoveries have opened this door.
Text by Mårten Lind
 Professor Hans Ronne
Professor Hans RonneDepartment of Forest Mycology and Plant Pathology
018-673223, hans.ronne@slu.se